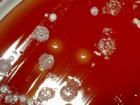
齲齒羅氏菌 齲齒羅氏菌

特徵
胞壁主要組分:丙氨酸、賴氨酸、谷氨酸,果糖、半乳糖、葡萄糖、核醇。DNA內G+C含量為65.4—69.7%。此菌需要有機氮才能生長。在營養瓊脂上生長貧乏;在腦心浸液瓊脂和胰示腖(trypticase)大豆瓊脂上形成乳脂白色菌落。不能在薩氏葡萄糖瓊脂上生長,有別於諾卡氏菌;後者有時產生氣絲和孢子,在蔗糖硝酸鹽瓊脂或營養瓊脂上生長。氧化而不發酵糖類。此菌與放線菌屬也比較近似,但後者嫌氣,觸酶陰性、不能液化明膠、凍化牛奶。
盤點世界上的微生物(五)
| 微生物是包括細菌、病毒、真菌以及一些小型的原生動物、顯微藻類等在內的一大類生物群體,它個體微小,卻與人類生活關係密切。涵蓋了有益有害的眾多種類,廣泛涉及健康、食品、醫藥、工農業、環保等諸多領域。 |